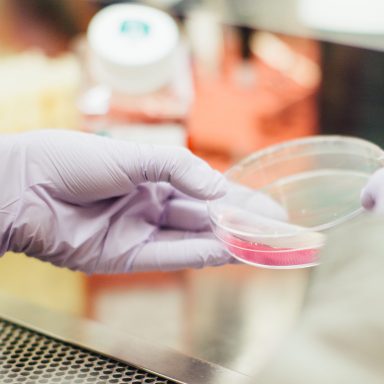

50 Possible Signs You May Have Colonial Mentality

Not liking or consuming literally any Filipino media. Seriously, you don’t like ONE Filipino song or band?

Not liking or consuming literally any Filipino media. Seriously, you don’t like ONE Filipino song or band?
Stop playing small if you know you want to play big, and stop telling yourself “this is good enough” if you know deep down you would love to do, create, and have so much more.

I refuse to lower standards just because fuckboys can’t seem to get it together and step their game up.

“Saying ‘because I said so.’ My dad and mom did this to me and I hated it. So now with my daughter, she knows exactly why I say no to something.”
“Cold death of the universe theory always spooks me. It’s the idea that the universe will eventually expand so far that it will become too cold to support life and it’ll just kinda go dark. It’s eerie and depressing.”

They won’t cheat on you: Most importantly, programmers spend a lot of time assessing compatibility. They will only commit when they are ready and, once they do, they will do whatever it takes to keep the relationship functioning.

You don’t ‘have time to date’. I’m sorry but that’s not a valid excuse. If you have time to sit on your ass and watch Netflix by yourself at midnight, you have time to go for drinks with a stranger and you certainly have time to play the field.

A funny thing happens when you disconnect from the social media hive mind. For the first time in ages, you actually feel like you’re connected to the real world again – far, far removed from the meaningless chatter of the cyber circle jerk and actually experiencing that trifling little thing we used to call “life” instead of repackaging it for clicks and shares.

“There are a lot of things I want to do in my life, and they don’t require a partner.”

Jobs are not so great. And they cause a lot of suffering. And you don’t really need them. Bear with me.

“Opened up a department store in the early hours to find someone already in the building. Looked on the video to see who it was and found a total of 10 seconds of something human like on all fours and around 15 seconds of someone with a distorted face but video did not show that person or thing leaving.”